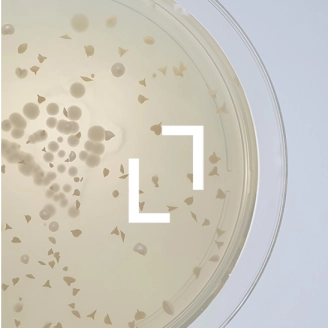

Les bienfaits des saccharomyces boulardii

✓ Levure probiotique
✓ Participe à l’équilibre de la flore intestinale et vaginale
✓ Résiste à l’acidité et à la température corporelle
✓ Consommée depuis des dizaines d’années
✓ Une des souches les plus étudiées au monde
S.boulardii est la seule levure considérée comme probiotique, c’est-à-dire pouvant interagir positivement avec l’organisme humain. D’où vient-elle ? Quelles sont ses propriétés ? Sa consommation est-elle sans danger ?
Sommaire :
- Quels sont les bienfaits de Saccharomyces boulardii ?
- Existe t-il des effets indésirables ?
- Définition de Saccharomyces boulardii
- L'histoire de Saccharomyces boulardii
Quels sont les bienfaits de Saccharomyces boulardii ? [2, 3]
S. boulardii est l’une des souches probiotiques les plus étudiées au monde, avec près d’une centaine d’études cliniques publiées, ayant évalué les effets de cette levure chez plus de 10 000 sujets.
Résistance et survie digestive
Afin d’exercer leurs effets, les probiotiques doivent parvenir vivants sur leur lieu d’action (l’intestin) et y survivre assez longtemps. S. boulardiiest particulièrement adaptée dans la mesure où elle se développe de manière optimale à la température de notre corps (37°C) et dans un milieu présentant une faible acidité (comme l’intestin grêle). Par ailleurs,S. boulardiirésiste bien à l’acidité de l’estomac.
Protection du microbiote
Les études scientifiques ont montré que S. boulardii n’est pas en mesure de coloniser l’intestin, car le microbiote naturellement présent l’en empêche. Cette propriété explique son excellente tolérance. Cependant, la levure peut exercer un effet protecteur vis-à-vis du microbiote en cas de dysbiose (due par exemple à une diarrhée ou la prise d’antibiotiques). En effet, la dysbiose est caractérisée par une réduction de la densité et de la diversité des bactéries et levures, qui ne peuvent plus exercer de fonction barrière. La protection assurée par S. boulardii est provisoire et disparaît lorsque l’équilibre du microbiote est retrouvé, généralement après 1 ou 2 mois, lui permettant d’assurer à nouveau sa fonction barrière.
Action globale sur l’intestin
Le mécanisme d’action de S. boulardii est complexe car la levure peut interagir à différents niveaux dans l’intestin :
- En adhérant aux microorganismes pathogènes, limitant leur déplacement
- En limitant la prolifération de microorganismes indésirables
- En modulant le système immunitaire, responsable de la lutte contre les pathogènes
- En renforçant l’intégrité de la muqueuse intestinale (effet trophique)
Les bienfaits de S. boulardii ont été étudiés principalement chez l’adulte et l’enfant confrontés à des diarrhées induites par les antibiotiques, ou lors d’une infection par la bactérie Clostridium difficile. Ces situations sont effectivement associées aux dysbioses les plus intenses (déséquilibre du microbiote). Les études ont montré l’intérêt d’une prise durant toute la période de prise des antibiotiques et durant les semaines qui suivent.
Santé vaginale
Plus récemment, des études se sont intéressées aux effets de S.boulardii sur la santé vaginale. Les chercheurs ont pu observer que, contrairement à ce que l’on pensait, les levures sont présentes dans la flore vaginale de la majorité des femmes en bonne santé, soulignant leur rôle possible dans l’équilibre de cette flore. Par la suite, plusieurs études ont étudié l’effet de S.boulardii chez des femmes à risque de développer des infections bactériennes ou fongiques (candidoses), montrant des résultats prometteurs. Ainsi, l’équilibre du microbiote vaginal semble reposer sur un bon équilibre entre bactéries et levures, comme c’est le cas pour le microbiote intestinal, soulignant l’intérêt d’une association entre bactéries et levures probiotiques.
Existe-t-il des effets indésirables ? [1, 2]
La consommation de S. boulardii est sans danger chez les enfants et adultes en bonne santé. Les femmes enceintes et allaitantes peuvent également consommer S. boulardii.
S. boulardii étant un microorganisme vivant, le risque théorique principal serait une infection induite par cette levure (fongémie). Aucun cas de fongémie n’a été observé au cours des 90 études réalisées chez l’Homme. Les rares effets indésirables qui ont pu être observés consistaient en des constipations très occasionnelles. La sécurité d’emploi de S. boulardii est entre autres liée à son incapacité à coloniser l’intestin et à pénétrer dans l’organisme.
Par précaution cependant, S. boulardii ne doit pas être consommée dans certains cas particuliers : lorsque le consommateur présente une défaillance grave du système immunitaire (lié à une maladie ou un traitement médicamenteux), lorsqu’une opération chirurgicale de l’intestin vient d’être réalisée ou en cas de présence d’un cathéter central veineux.
Nos solutions de santé
Définition de Saccharomyces boulardii
Saccharomyces boulardii est une levure probiotique, consommée depuis des dizaines d’années et dont les bienfaits ont fait l’objet de centaines d’études et de publications scientifiques. Cette levure fait partie de la famille (genre) Saccharomyces, la même que l’une des levures les plus connues : la levure de bière ou levure de boulanger, Saccharomyces cerevisiae. Les scientifiques ont longtemps débattu sur la question de savoir si S. boulardii était réellement distincte de S. cerevisae. Les dernières données montrent qu’il existe bel et bien des différences, mais qu’il faut considérer S. boulardii comme une souche particulière de S. cerevisiae. Il serait donc plus juste de parler de Saccharomyces cerevisiae boulardii. Cela signifie que S. boulardii est une « fille » de S. cerevisiae qui a évolué, lui conférant des propriétés particulières. Une différence importante : contrairement à sa parente, S. boulardii n’est pas capable de former des hyphes, des excroissances permettant d’envahir les tissus vivants. En revanche, elle est plus résistante à l’acidité et aux températures du corps humain, une caractéristique intéressante qui accroit ses chances de survie dans l’intestin.
Étant une levure, S. boulardii est un organisme eucaryote, beaucoup plus gros et évolué qu’une bactérie (procaryote). Contrairement à ces dernières, les levures possèdent un noyau qui renferment leur ADN et des mitochondries qui produisent de l’énergie, comme chaque cellule de notre organisme. S. boulardii se développe par bourgeonnement, à partir duquel une nouvelle levure croit, puis se détache (plus ou moins) de la cellule-mère. C’est ainsi que l’on peut l’observer au microscope.
S. boulardii est, à ce jour, la seule levure considérée comme probiotique, c’est-à-dire pouvant interagir positivement avec l’organisme humain. Tous les autres probiotiques sont des bactéries, le plus généralement des ferments lactiques.
L'histoire de Saccharomyces boulardii [1]
Saccharomyces cerevisiae a une longue histoire d'utilisation en boulangerie et pour le brassage, mais cette levure n’a que rarement été étudiée pour ses propriétés bénéfiques chez l’Homme. Sa parente, la souche S. boulardii, a été découverte par un microbiologiste français, Henri Boulard, en 1920 alors qu'il était en Indochine à la recherche de nouvelles souches de levure pouvant être utilisées dans les processus de fermentation. Il était en visite lors d'une épidémie et a remarqué que certaines personnes qui n'avaient pas été touchées, buvaient un thé spécial. Ce thé était préparé en prenant la peau extérieure de fruits tropicaux (litchi et mangoustan) et en les faisant cuire pour en faire du thé. Il a réussi à en isoler une souche spéciale de levure qu'il nomma «Saccharomyces boulardii». Un brevet a été déposé, suite à cette découverte, tombé depuis des années dans le domaine public. S. boulardii a fait l’objet d’un nombre considérable d’études à partir de 1947, à la fois chez l’Homme, mais également in vitro, afin de comprendre les mécanismes d’action de cette levure.
SOURCES
- McFarland, L.V., Systematic review and meta-analysis of Saccharomyces boulardii in adult patients. World journal of gastroenterology, 2010. 16(18): p. 2202-2222. https://pubmed.ncbi.nlm.nih.gov/20458757
- Pais, P., et al., Saccharomyces boulardii: What Makes It Tick as Successful Probiotic? J Fungi (Basel), 2020. 6(2). https://www.ncbi.nlm.nih.gov/pubmed/32512834
- Bohbot J. M. & Zhioua F. "Intérêt de Saccharomyces boulardii CNCM I-745 dans la prise en charge des infections vulvo-vaginales." Gynécologie Obstétrique Fertilité & Sénologie, 2021. 49(9): 716-723. https://pubmed.ncbi.nlm.nih.gov/33933670/

Notre équipe médico-scientifique réunit 8 experts aux compétences complémentaires : docteurs en sciences, docteure en pharmacie, responsables qualité et réglementaire, cheffes de produit et responsable marketing.
Cette diversité de profils permet de garantir une approche globale, alliant expertise scientifique, maîtrise réglementaire et compréhension des besoins des consommateurs. Chaque projet bénéficie ainsi d’une validation rigoureuse, de la conception à la mise à disposition des compléments alimentaires.